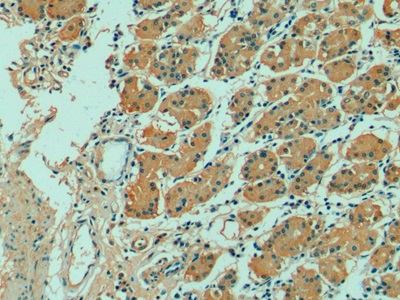

Monoclonal Antibody to Fibroblast Growth Factor 21 (FGF21)
- Product No.MAC918Hu24
- Organism SpeciesHomo sapiens (Human) Same name, Different species.
- SourceMonoclonal antibody preparation
- HostMouse
- Potency (Clone Number)C8
- Ig Isotype IgG2b Kappa
- PurificationProtein A + Protein G affinity chromatography
- LabelNone
- Immunogen RPC918Hu01-Recombinant Fibroblast Growth Factor 21 (FGF21)
- Buffer Formulation0.01M PBS, pH7.4, containing 0.05% Proclin-300, 50% glycerol.
- TraitsLiquid
- Concentration1mg/mL
- Organism Species Moren/a
- ApplicationsIHC
If the antibody is used in flow cytometry, please check FCM antibodies. - DownloadInstruction Manual
- UOM 20µl100µl 200µl 1ml 10ml
- FOB
US$ 90
US$ 210
US$ 300
US$ 750
US$ 3000
For more details, please contact local distributors!
SPECIFITY
The antibody is a mouse monoclonal antibody raised against FGF21. It has been selected for its ability to recognize FGF21 in immunohistochemical staining and western blotting.
USAGE
Western blotting: 0.5-2µg/mL;
Immunohistochemistry: 5-20µg/mL;
Immunocytochemistry: 5-20µg/mL;
Optimal working dilutions must be determined by end user.
STORAGE
Store at 4°C for frequent use. Stored at -20°C in a manual defrost freezer for two year without detectable loss of activity. Avoid repeated freeze-thaw cycles.
STABILITY
The thermal stability is described by the loss rate. The loss rate was determined by accelerated thermal degradation test, that is, incubate the protein at 37°C for 48h, and no obvious degradation and precipitation were observed. The loss rate is less than 5% within the expiration date under appropriate storage condition.
GIVEAWAYS
INCREMENT SERVICES
-
 Antibody Labeling Customized Service
Antibody Labeling Customized Service
-
 Protein A/G Purification Column
Protein A/G Purification Column
-
 Staining Solution for Cells and Tissue
Staining Solution for Cells and Tissue
-
 Positive Control for Antibody
Positive Control for Antibody
-
 Tissue/Sections Customized Service
Tissue/Sections Customized Service
-
 Phosphorylated Antibody Customized Service
Phosphorylated Antibody Customized Service
-
 Western Blot (WB) Experiment Service
Western Blot (WB) Experiment Service
-
 Immunohistochemistry (IHC) Experiment Service
Immunohistochemistry (IHC) Experiment Service
-
 Immunocytochemistry (ICC) Experiment Service
Immunocytochemistry (ICC) Experiment Service
-
 Flow Cytometry (FCM) Experiment Service
Flow Cytometry (FCM) Experiment Service
-
 Immunoprecipitation (IP) Experiment Service
Immunoprecipitation (IP) Experiment Service
-
 Immunofluorescence (IF) Experiment Service
Immunofluorescence (IF) Experiment Service
-
 Buffer
Buffer
-
 DAB Chromogen Kit
DAB Chromogen Kit
-
 SABC Kit
SABC Kit
-
 Long-arm Biotin Labeling Kit
Long-arm Biotin Labeling Kit
-
 Real Time PCR Experimental Service
Real Time PCR Experimental Service
| Magazine | Citations |
| Lipids in Health and Disease | Dietary moderately oxidized oil induces expression of fibroblast growth factor 21 in the liver of pigs Lipidworld: source |
| Endocrinology | Orphan nuclear receptor Nur77 mediates fasting-induced hepatic fibroblast growth factor 21 expression Endocrine:Source |
| Biochemical and Biophysical Research Communications | Alpha lipoic acid induces hepatic fibroblast growth factor 21 expression via up-regulation of CREBH Pubmed:25449271 |
| Free Radic Biol Med | Skeletal muscle increases FGF21 expression in mitochondrial disorders to compensate for energy metabolic insufficiency by activating the mTOR–YY1–PGC1α pathway PubMed: 25843656 |
| Journal of diabetes and its complications | Associations between FGF21, osteonectin and bone turnover markers in type 2 diabetic patients with albuminuria. pubmed:27916484 |
| American journal of the medical sciences | Association of Bone Metabolic Markers With Diabetic Retinopathy and Diabetic Macular Edema in Elderly Chinese Individuals With Type 2 Diabetes Mellitus pubmed:29078839 |
| Frontiers in Physiology | Ileal Transposition Surgery Decreases Fat Mass and Improves Glucose Metabolism in Diabetic GK Rats: Possible Involvement of FGF21 Pubmed:29593555 |
| Некоторые аспекты транспортной системы метаболизма железа в зависимости от степени синдрома перегрузки железом у детей с хроническим … | |
| Physiol Res | Fibroblast growth factor 21 (FGF21) in children and adolescents with chronic kidney disease. Pubmed: 32469231 |
| Chinese Journal of Osteoporosis | 2 型糖尿病患者血清FGF21, 骨连结蛋白和骨转换指标的相关性研究. |
| Sci Rep | Ileal transposition helps to regulate plasma hepatokine levels in obese Zucker (Crl: ZUC (ORL)-Lepr fa) rats 33833309 |
| Nutrients | The Speed of Ingestion of a Sugary Beverage Has an Effect on the Acute Metabolic Response to Fructose |
| Medicine (Baltimore) | Association of serum fibroblast growth factor 21 with kidney function in a population-based Chinese cohort 34918690 |
| Annals of Agricultural and Environmental Medicine | Oxidative stress-induced growth inhibitor 1 in alcohol-induced liver cirrhosis 34969228 |
| J Magn Reson Imaging | Water Specific MRI T1 Mapping for Evaluating Liver Inflammation Activity Grades in Rats With Methionine‐Choline‐Deficient Diet‐Induced Nonalcoholic Fatty Liver … Pubmed:35212074 |
| Lab Invest | Fibroblast growth factor 21, a stress regulator, inhibits Drp1 activation to alleviate skeletal muscle ischemia/reperfusion injury Pubmed:35488034 |
| Molecular Biology Reports | Umbilical cord-derived mesenchymal stem cell conditioned medium reverses neuronal oxidative injury by inhibition of TRPM2 activation and the JNK signaling … Pubmed:35585377 |
| High Circulating Fibroblast Growth Factor-21 Levels as a Prognostic Marker in Fatty Pancreas Patients |